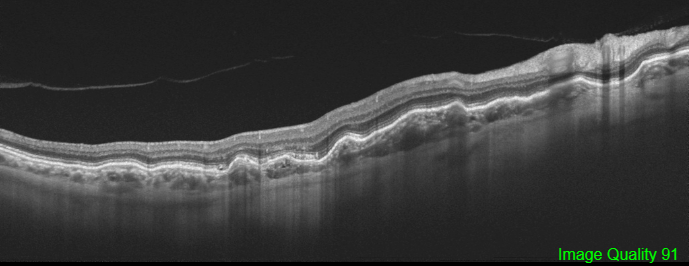
File:Choroidal Folds OCT.png

File:Choroidal Folds OCT.png
From EyeWiki
Choroidal_Folds_OCT.png (689 × 266 pixels, file size: 158 KB, MIME type: image/png)
Optical coherence tomography shows the characteristics undulations of the RPE consistent with choroidal folds with a nearly flat retinal surface and a variable retinal thickness, increasing in correspondence to the valleys and reducing in the crests
File history
Click on a date/time to view the file as it appeared at that time.
| Date/Time | Thumbnail | Dimensions | User | Comment | |
|---|---|---|---|---|---|
| current | 10:19, November 9, 2020 | 689 × 266 (158 KB) | Manuel.Marques (talk | contribs) | Optical coherence tomography shows the characteristics undulations of the RPE consistent with choroidal folds with a nearly flat retinal surface and a variable retinal thickness, increasing in correspondence to the valleys and reducing in the crests |
You cannot overwrite this file.
File usage
The following page uses this file: